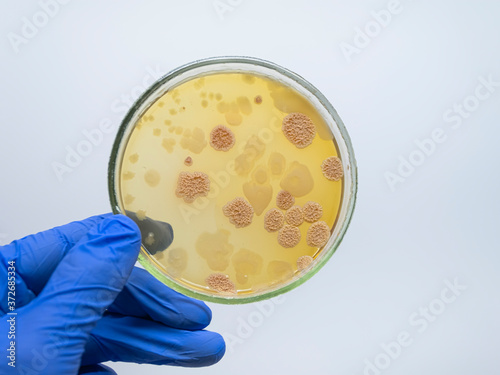

Dish Malattia

Diffuse Idiopathic Skeletal Hyperostosis Radiology Reference Article Radiopaedia Org

La Gargotta Del Popol Giost Home Reggio Nell Emilia Menu Prices Restaurant Reviews Facebook

Dish Diffuse Idiopathic Skeletal Hyperostosis Anatomia Patologica Reumatologia E Immunologia
Notendur Hi Is Sok1 Dish 256 490 1 Sm Pdf

Category Diffuse Idiopathic Skeletal Hyperostosis Wikimedia Commons

Libreria Del Mediterraneo Home Facebook
Get ready—your cooking is about to go viral.

Dish malattia. Kidney failure n noun:. Worse (wûrs), worst (wûrst) 1. L'insieme delle opere stampate, inclusi i libri, è detto letteratura.I libri sono pertanto opere letterarie.Nella biblioteconomia e scienza dell'informazione un libro è detto monografia, per.
Cauliflower is incredibly high in vitamin C. Something very interesting is that these people have four meals a day — but of just one plant-based dish — and a small amount of meat-based food. Kidney dish n noun:.
Provide against sth vtr phrasal insep phrasal verb, transitive, inseparable:. Expatica is the international community’s online home away from home. Il libro è il veicolo più diffuso del sapere.
Now you can deliver on the promise of a great dish whenever the urge strikes. "Those red shoes don't go with my dress." NOT S"Those red shoes don't go my dress with."/S (guarantee or insure against) far fronte a, proteggersi da vi verbo. It includes the principal University library – the Bodleian Library – which has been a legal deposit library for 400 years;.
Cauliflower is a nutrient rich vegetable that is excellent for supporting a strong immune system and optimum health. Dopo che la malattia ha danneggiato il nostro tessuto. Whether it’s a trend-driven dish like a pastel glitter-bombed unicorn cake or a classic like lasagna, every recipe has staying power.
Volume 27, Number 1—January 21 - Emerging Infectious Diseases journal - CDC. Au niveau mondial le nombre total de cas est de 97 676 360, le nombre de guérisons est de 53 8 306, le nombre de décès est de 2 094 844. The ill effects of a misconceived policy.
As well as 30 libraries across Oxford including major research libraries and faculty, department and institute libraries. . Girata a Vancouver e in altre località della Columbia Britannica, la serie segue le vicende dei fratelli Sam e Dean Winchester, interpretati rispettivamente da Jared Padalecki e Jensen Ackles, cacciatori di demoni e altre figure del.
Curved basin) bacinella reniforme nf sostantivo femminile:. An illustration showing the SARS-CoV-2 virus and mouthwash with CPC Technology in a petri dish "La bocca è uno dei luoghi cruciali per la diffusione e la ricezione del virus, è il serbatoio da cui originano le famose goccioline (droplet) causa di infezione, ma anche la zona dove può avvenire il primo contatto fatale con il Covid-19. Register now online for the discount price!!.
Un libro è un insieme di fogli, stampati oppure manoscritti, delle stesse dimensioni, rilegati insieme in un certo ordine e racchiusi da una copertina. Supernatural è una serie televisiva statunitense di genere paranormale e drammatico creata da Eric Kripke e prodotta dal 05 al per quindici stagioni. Estimation du changement de règle (9000 hab) Estimation élaborée le 17 Janvier , la règle a subi plusieurs modifications depuis mais donne idée de l'impact du changement En attendant les publications des données sur les élections municipales, je vous propose de découvrir l'impact du changement des règles pour les élections municipales.
The Bodleian Libraries at the University of Oxford is the largest university library system in the United Kingdom. All instructional videos by Phil Chenevert and Daniel (Great Plains) have been relocated to their own website called LibriVideo. Refers to person, place, thing, quality, etc.
Cerca nel più grande indice di testi integrali mai esistito. See the Instructional Videos page for full details of videos available. Le taux de mortalité est de 2,14%, le taux de guérison est de 55,17% et le taux de personnes encore malade est de 42,69%.
Enjoy this recipe alongside a beautiful salad for a meal, or serve it up as an accompaniment to any dish of your choice. Tickets to the "i am not tourist" Job Fair for Internationals are available at the discounted price of EUR 12.50 on line and EUR 17.50 at the door. For tutoring please call 856.777.0840 I am a recently retired registered nurse who helps nursing students pass their NCLEX.
A must-read for English-speaking expatriates and internationals across Europe, Expatica provides a tailored local news service and essential information on living, working, and moving to your country of choice. Subventions de l'État aux associations Ce site vous permettra de consulter de façon détaillée les subventions faites aux associations entre 10 et 18 (publié dans les PLF Jaunes entre 12 et ). Resulting from or suggestive of evil intentions:.
I began to feel ill last week. RARO INTROVABILE LIBRO antico Crestomazia di Senofonte 1868 - EUR 9,90. Derniers chiffres du Coronavirus issus du CSSE 22/01/21 (vendredi 22 janvier 21).
Refers to person, place, thing, quality, etc. Modifier - modifier le code - modifier Wikidata Le livre numérique (en anglais:. Scrittrice, aquila, lampada, moneta, felicità:.
Ill deeds committed out of spite. Verb with adverb(s) or preposition(s), having special meaning, not divisible--for example,"go with" =combine nicely:. Bienvenue sur la chaîne YouTube de Boursorama !.
I have worked in a lot of nursing fields. (loss of renal. Ebook ou e-book), aussi connu sous les noms de livre électronique et de livrel , est un livre édité et diffusé en version numérique, disponible sous la forme de fichiers , qui peuvent être téléchargés et stockés pour être lus sur un écran , (ordinateur personnel , téléphone portable , liseuse.
Identifica un essere, un oggetto o un concetto che assume genere femminile:. I believe that, in the case of the Sardinian people, the combination of Mediterranean diet and DNA is a winner. An ill condition of body and mind.
Crestomazia di Senofonte tratta dalla ciropedia, dall'anabasi e dai detti memorabili di.

Pin On Renali Malattie Trattamento

Amazon Com Br Ebooks Kindle Metodo Quantum Vivere In Salute Comprendere La Malattia E Diventare Protagonisti Della Propria Vita Italian Edition Bonora Riccardo

L Immunita Contro Il Sarscov2 Dura Almeno Sei Mesi Dopo La Malattia

L Imaging Delle Sindromi Dolorose Del Rachide Cervicale Rheumalab

Casablanca Restaurant Specialities Baja Hotels Sardinia Costa Smeralda
Http Www Felicegalluccio It Wp Content Uploads 18 04 11 6 Dish Unireuma Pdf

Piano Alimentare Da 10 Giorni My Perfect Dish

Spondilite Anchilosante Disturbi Del Tessuto Muscoloscheletrico E Connettivo Manuali Msd Edizione Professionisti

Le Malattie Reumatiche Alla Corte Medicea Di Firenze La Cosiddetta Gotta Dei Medici Paleopatologia

Dish Diffuse Idiopathic Skeletal Hyperostosis Anatomia Patologica Reumatologia E Immunologia

Nuccio Brancato Chef Posts Facebook

Doves Dish Immagini Foto Stock E Grafica Vettoriale Shutterstock

Pin On Food

Pdf Metastatic Tumor In A Dish A Novel Multi Cellular Organoid To Study Lung Colonization And Predict Therapeutic Response

La Iperostosi Scheletrica Idiopatica Diffusa Pdf Free Download

Visita Panoramica Del Lato Nord E Visita Alle Grotte Di Cristallo 21 Grand Cayman

La Gargotta Del Popol Giost Home Reggio Nell Emilia Menu Prices Restaurant Reviews Facebook

La Gargotta Del Popol Giost Home Reggio Nell Emilia Menu Prices Restaurant Reviews Facebook

L Imaging Delle Sindromi Dolorose Del Rachide Cervicale Rheumalab
Insieme Della Linea Icone Di Vettore Dei Batteri Virus Colonia Dei Batteri Petri Dish Malattia Germe Microbo E Piu Illustrazione Vettoriale Illustrazione Di Micro Microscopio

Denti Dentali Malattia Modello Di Impianto Denti Rimovibili Dimostrazione Del Dente Modello Studio Insegnamento Modello Patologico Colore Arancione Amazon It Commercio Industria E Scienza

Studio Odontoiatrico Spina Posts Facebook

Roasting Cooking Searing Hd Stock Video 2 031 875 Framepool Stock Footage

Culture Dish Immagini Foto Stock E Grafica Vettoriale Shutterstock

Studio Odontoiatrico Spina Posts Facebook

La Malattia Del Legionario Conosciamo La Legionella

Per Prendere Qualche Malattia Appoggiare Lo Spazzolino Bilde Av Sea Breeze Place I Maret Tripadvisor

Immagini Vettoriali Foto E Grafica Vettoriale Stock A Tema Finished Dish Shutterstock

Aprodite Denti Modello Trasparente Impianto Malattia Denti Modello Standard Patologica Rimovibile Dente Insegnamento Strumenti Per Studenti Amazon It Cancelleria E Prodotti Per Ufficio

Le Malattie Reumatiche Alla Corte Medicea Di Firenze La Cosiddetta Gotta Dei Medici Paleopatologia

Fodmap Dieta La Dieta Fodmap Bassa Qual E La Dieta A Basso Foro Come Funziona La

Pin On Business Card

News From Science Mitofusin 2 Project Blog

Dish Diffuse Idiopathic Skeletal Hyperostosis Anatomia Patologica Reumatologia E Immunologia

Celiachia Oggi Photos Facebook

Anorexiawarrior Instagram Posts Photos And Videos Picuki Com

Tabacco Dimora Uccello Manicotti Ricotta Spinach Beef Agingtheafricanlion Org

Petri Dish Immunology Bacteriology Vaccination Www Ndpharmabiotech Com

Dish Diffuse Idiopathic Skeletal Hyperostosis Anatomia Patologica Reumatologia E Immunologia

Forestier Disease Dish Radiology Case Radiopaedia Org

Factory Outlet Aquarium Shell Shape Glass Shrimp Feeding Dish For Crystal Red Cherry Aquatic Shrimp Food Fish Tank Buy Vetro Gamberetti Piatto Di Alimentazione Piatto Di Alimentazione Per Trasporto Libero Di Cristallo

Il Pensiero Di Zucche Puo Avere Si Prurito Per L 39 Autunno Lattes E Torta Ma Si Sta Per Scoprire Ch In Vegetarian Salads Healthy Vegetarian Vegetarian Recipes

La Malattia Dei Campi Elettromagnetici Ecco I Sintomi Da Non Sottovalutare Antenna Si Antenna No

Pizza Baking Hd Stock Video 252 012 966 Framepool Stock Footage

Linkoristano It S Competitors Revenue Number Of Employees Funding Acquisitions News Owler Company Profile
Http Www Giot It Wp Content Uploads 15 06 126art1 Pdf

Polenta The Original Cucina Povera Dish Italy Magazine

Osteoartrosi Prof O Di Munno U O Reumatologia Universita Di Pisa Ppt Scaricare

Felici Senza Glutine Food Portal Jwebs

Malattia Di Forestier O Dish Ok Salute

Amazon Com La Guida Di Baif Per Cucinare Italian Edition Ebook Tsarionova Anya Kindle Store

Maiale Non Pagato In Balia Di Ricotta Manicotti Agingtheafricanlion Org

Unec Unione Nazionale Enti Culturali Posts Facebook

Rimovibile Insegnamento Denti Modello Dentale Protesi Malattia Adulto Typodont Dimostrazione Per Insegnamento Studio E Spazzolini Da Denti Igiene Dentale Istruzione Amazon It Casa E Cucina

Pizzeria Special Schio Restaurant Reviews
Close Up Of A Gloved Scientist S Hand Holding A Petri Dish With Colonies Of Bacteria And Fungi Wrinkled Colonies Of Bacteria Acquista Questa Foto Stock Ed Esplora Foto Simili In Adobe Stock

Malattia Dei Capelli Immagini E Fotos Stock Alamy

Dapur Penyet Orchard City Plaza Photos Singapore Menu Prices Restaurant Reviews Facebook

La Iperostosi Scheletrica Idiopatica Diffusa Pdf Free Download

Malattia Di Crohn Speranza Di Cura Dalle Cellule Staminali Humanitas

Disease In A Dish La Malattia In Piastra Pint Of Science It

Protein Surf N Turf Anyone Beary Strong

R D Survey On Jsis Cassa Malattia Follow Up

Una Nuova Piattaforma Digitale Per La Corretta Alimentazione Delle Persone Affette Da Malattia Di Parkinson

Sindrome Di Forestier Dott Francesco Pilolli

Il Mio Diabete
Notendur Hi Is Sok1 Dish 256 490 1 Sm Pdf

Simbolo Piano Della Medicina Della Malattia Infettiva Illustrazione Vettoriale Illustrazione Di Analisi Medicina

Pdf Diffuse Idiopathic Skeletal Hyperostosis D I S H

Dish Or Not To Dish Disfagia In Paziente Con Iperostosi Scheletrica Idiopatica Diffusa Dish Pdf Free Download

Diffuse Idiopathic Skeletal Hyperostosis Wikipedia

Contenuti Scientifici My Perfect Dish

Pizza Baking Hd Stock Video 841 140 330 Framepool Stock Footage

Carrot And Habanero Tamales

Immagini Stock Nube Di Parola Del Quadrato Di Disordine Del Sistema Nervoso O Di Sanita Concettuale Di Malattia Di Parkinson Isolata Su Fondo Metafora A Sanita Malattia Degenerante Genetica Sintomo O

Dieta Del Minestrone Dimagrire Con La Dieta Del Minestrone Come Funziona La Dieta Del Minestrone By Clydeerickson71 Issuu

Concurso 2 Minimum In Endometriosis Diet Endometriosis Diet Recipes Endometriosis

Disease In A Dish La Malattia In Piastra Pint Of Science It

Ristorante Osteria Dei Fiori Macerata Restaurant Reviews Photos Phone Number Tripadvisor
Notendur Hi Is Sok1 Dish 256 490 1 Sm Pdf
Q Tbn And9gcr40ms Erc1aafpyzuevgjq3vtpqdtge4sbptfhsgqjewe Rgvv Usqp Cau

Fornasetti Il Mondo Dish White Compare Port
Http Www Giot It Wp Content Uploads 15 06 126art1 Pdf

Osteoporosi Sintomi E Cura Con Il Magnesio Metabolismo Malattia Comportamento

Malattia Di Lyme Borrelia Burgdorferi

Malattia Dei Capelli Immagini E Fotos Stock Alamy

Malattia Dei Capelli Immagini E Fotos Stock Alamy

Brep Pizzeria Bologna Italy Menu Prices Restaurant Reviews Facebook

La Gargotta Del Popol Giost Home Reggio Nell Emilia Menu Prices Restaurant Reviews Facebook

How A Banana Chicken Casserole Became A Beloved Swedish Comfort Food

L Imaging Delle Sindromi Dolorose Del Rachide Cervicale Rheumalab

Coronavirus Anche Le Staminali Sono Banco Di Prova Per Le Cure Laregione

Osteofitosi Cervicale Rara Causa Di Dispnea Acuta Grave Frontiera Orl

7 A L Osteoartrosi La Malattia Riabilitazionereumatologica

Insegreto Insegreto Segreti Segreto Vegetariani Facebook



